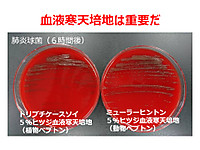

お弁当 作り置き 冷凍 ダイエット (402 無料画像)
お弁当 冷凍ストックを詰めただけ🙈 :.。 。.:+・゚・✽:.。 。.:+・゚・✽:.。 。.:+・゚・✽:.。 。.:+・゚・手作りする人を増やしたい♡大学生 男子わっぱ弁当 作り置き 冷凍保存 健康 食物繊維 腸活 血糖値 ダイエット 免疫力 管理栄養士 レシピ開発 料理家 節約美容料理。
ダイソー 100均グッズで朝のお弁当作りが時短&ラクに!「お弁当作り置き冷凍トレー」試してみた!『あたらしい日日』こんな時代のニューノーマルな暮らし方。食と農、生活情報をお届けします。
ダイエット弁当レシピ 簡単!冷凍&作り置きで1食平均114円!5年で70万円得して痩せる節約ランチボックス 2017年6月- 50kgダイエット した港区芝浦IT社長ブログ。
のんのん🍠🌻ダイエット豚肉弁当を平日5日分まとめて作り置き。 豚肉の中でも低脂質低カロリーな部位、豚ヒレ肉の冷凍弁当を作ったよ!ビタミンB1を多く含む豚肉。特に豚ヒレ肉は他の豚肉の部位に比べて圧倒的に低脂質低カロリー。 ビタミンB1は糖質の分解を助けて。
平日5日分の、節約ダイエット弁当作り置き。, 丸ごと弁当を冷凍するよ!,節約ヘルシーハンバーグ , 玉ねぎ1 2個, 鶏むねミンチ400g,もやし1袋, 卵1つ, 塩胡椒適量, ポン酢大さじ2, オリーブオイル小さじ2ほど, ①玉ねぎ、もやしをみじん切りにする。,②ボウルに、みじんぎりにした玉ねぎともやし、鶏むねミンチ、卵、塩胡椒、ポン酢を合わせて、粘り気が出るまでこねる。,。
よろずや🍑すもも 100日後に10kg痩せるぽっちゃり修行中1週間分の冷凍弁当、完成🍱 平日ラクするための作り置き!・ω・ つ作り置き 作り置きおかず 冷凍弁当 作り置き弁当お弁当作り 冷凍保存 常備菜 節約ごはん 時短レシピ。
夏に向けてダイエット中のお魚の冷凍弁当を平日5日分まとめて作り置き。 🌻1食分のおおよその栄養素🌻魚+米100g+ブロッコリー•カロリー 394.2 •タンパク質 28.4 •脂質 16.4 •炭水化物 38.0材料塩サバ2切 骨取り鮭2切 銀鮭を使用しました鰹節お好きなだけ 海苔5枚 ①塩サバと鮭は、キッチンペーパーで両面の水分をよく拭き取る。
20分つなナゲット5食分の冷凍作り置きおかず🍱 その他の痩せる簡単5日分の 冷凍弁当レシピ、冷凍おかずレシピは@rakuraku_tsukuriokiから❣️ 材料と調味料🔽 ◇ナゲット材料・にんじん 1本 ・木綿豆腐 2丁 ・玉ねぎ 1個 ・ツナ 250g調味料・塩。
ダイエット中の冷やしそば冷凍弁当を平日5日分まとめて作り置き, ダイエット中でも麺が食べたい〜!って時あるよね!, そんな時は、十割そばを使おう!,十割そばは低G I食品で、血糖値の急上昇を防いでくれるため、太りにくい食材です。, ただ、低G Iだからといっても、たくさんの量を食べてしまうのは,返って太る原因に!麺系は、量を食べ過ぎてしまうので,。
トレーニーのよくやる作り置きの冷凍弁当作ってみた😊 メインは脂質の少ないニチレイのむねからメインで🥳 海苔弁当システムで最高でしょ😍※ブロッコリー忘れてた😭 これで日々の昼ご飯は確保された😊👍筋肉飯冷凍弁当筋トレトレーニーダイエットニチレイ。
ダイエット豚肉弁当を平日5日分まとめて作り置き。, 豚肉の中でも低脂質低カロリーな部位、豚ヒレ肉の冷凍弁当を作ったよ!,ビタミンB1を多く含む豚肉。特に豚ヒレ肉は他の豚肉の部位に比べて圧倒的に低脂質低カロリー。, ビタミンB1は糖質の分解を助けてくれたり、疲労回復、,血行を良くしたり、冷え性改善も期待できてダイエット向きだよ!, 使用しているタッパーは480mlのサイズです。,。
2日間の塩抜き生活で1キロ減!塩抜きダイエット弁当を平日5日分まとめて冷凍作り置き作業, 🌻1食分のおおよその栄養素🌻,おかず+さつまいも120g , ・カロリー312, ・タンパク質25.6, ・脂質7.2, ・炭水化物43.6 うち糖質37.2食物繊維6.4 ,材料 , ・皮を取った鶏もも肉600g, ・ブロッコリー1株, ・舞茸1パック, ・油小さじ1,。
のんのん🍠🌻平日5日分の、節約ダイエット弁当作り置き。 丸ごと弁当を冷凍するよ!節約ヘルシーハンバーグ玉ねぎ 1 2個 鶏むねミンチ400g もやし 1袋 卵 1つ 塩胡椒 適量 ポン酢 大さじ2 オリーブオイル 小さじ2ほど ①玉ねぎ、もやしをみじん切りにする。